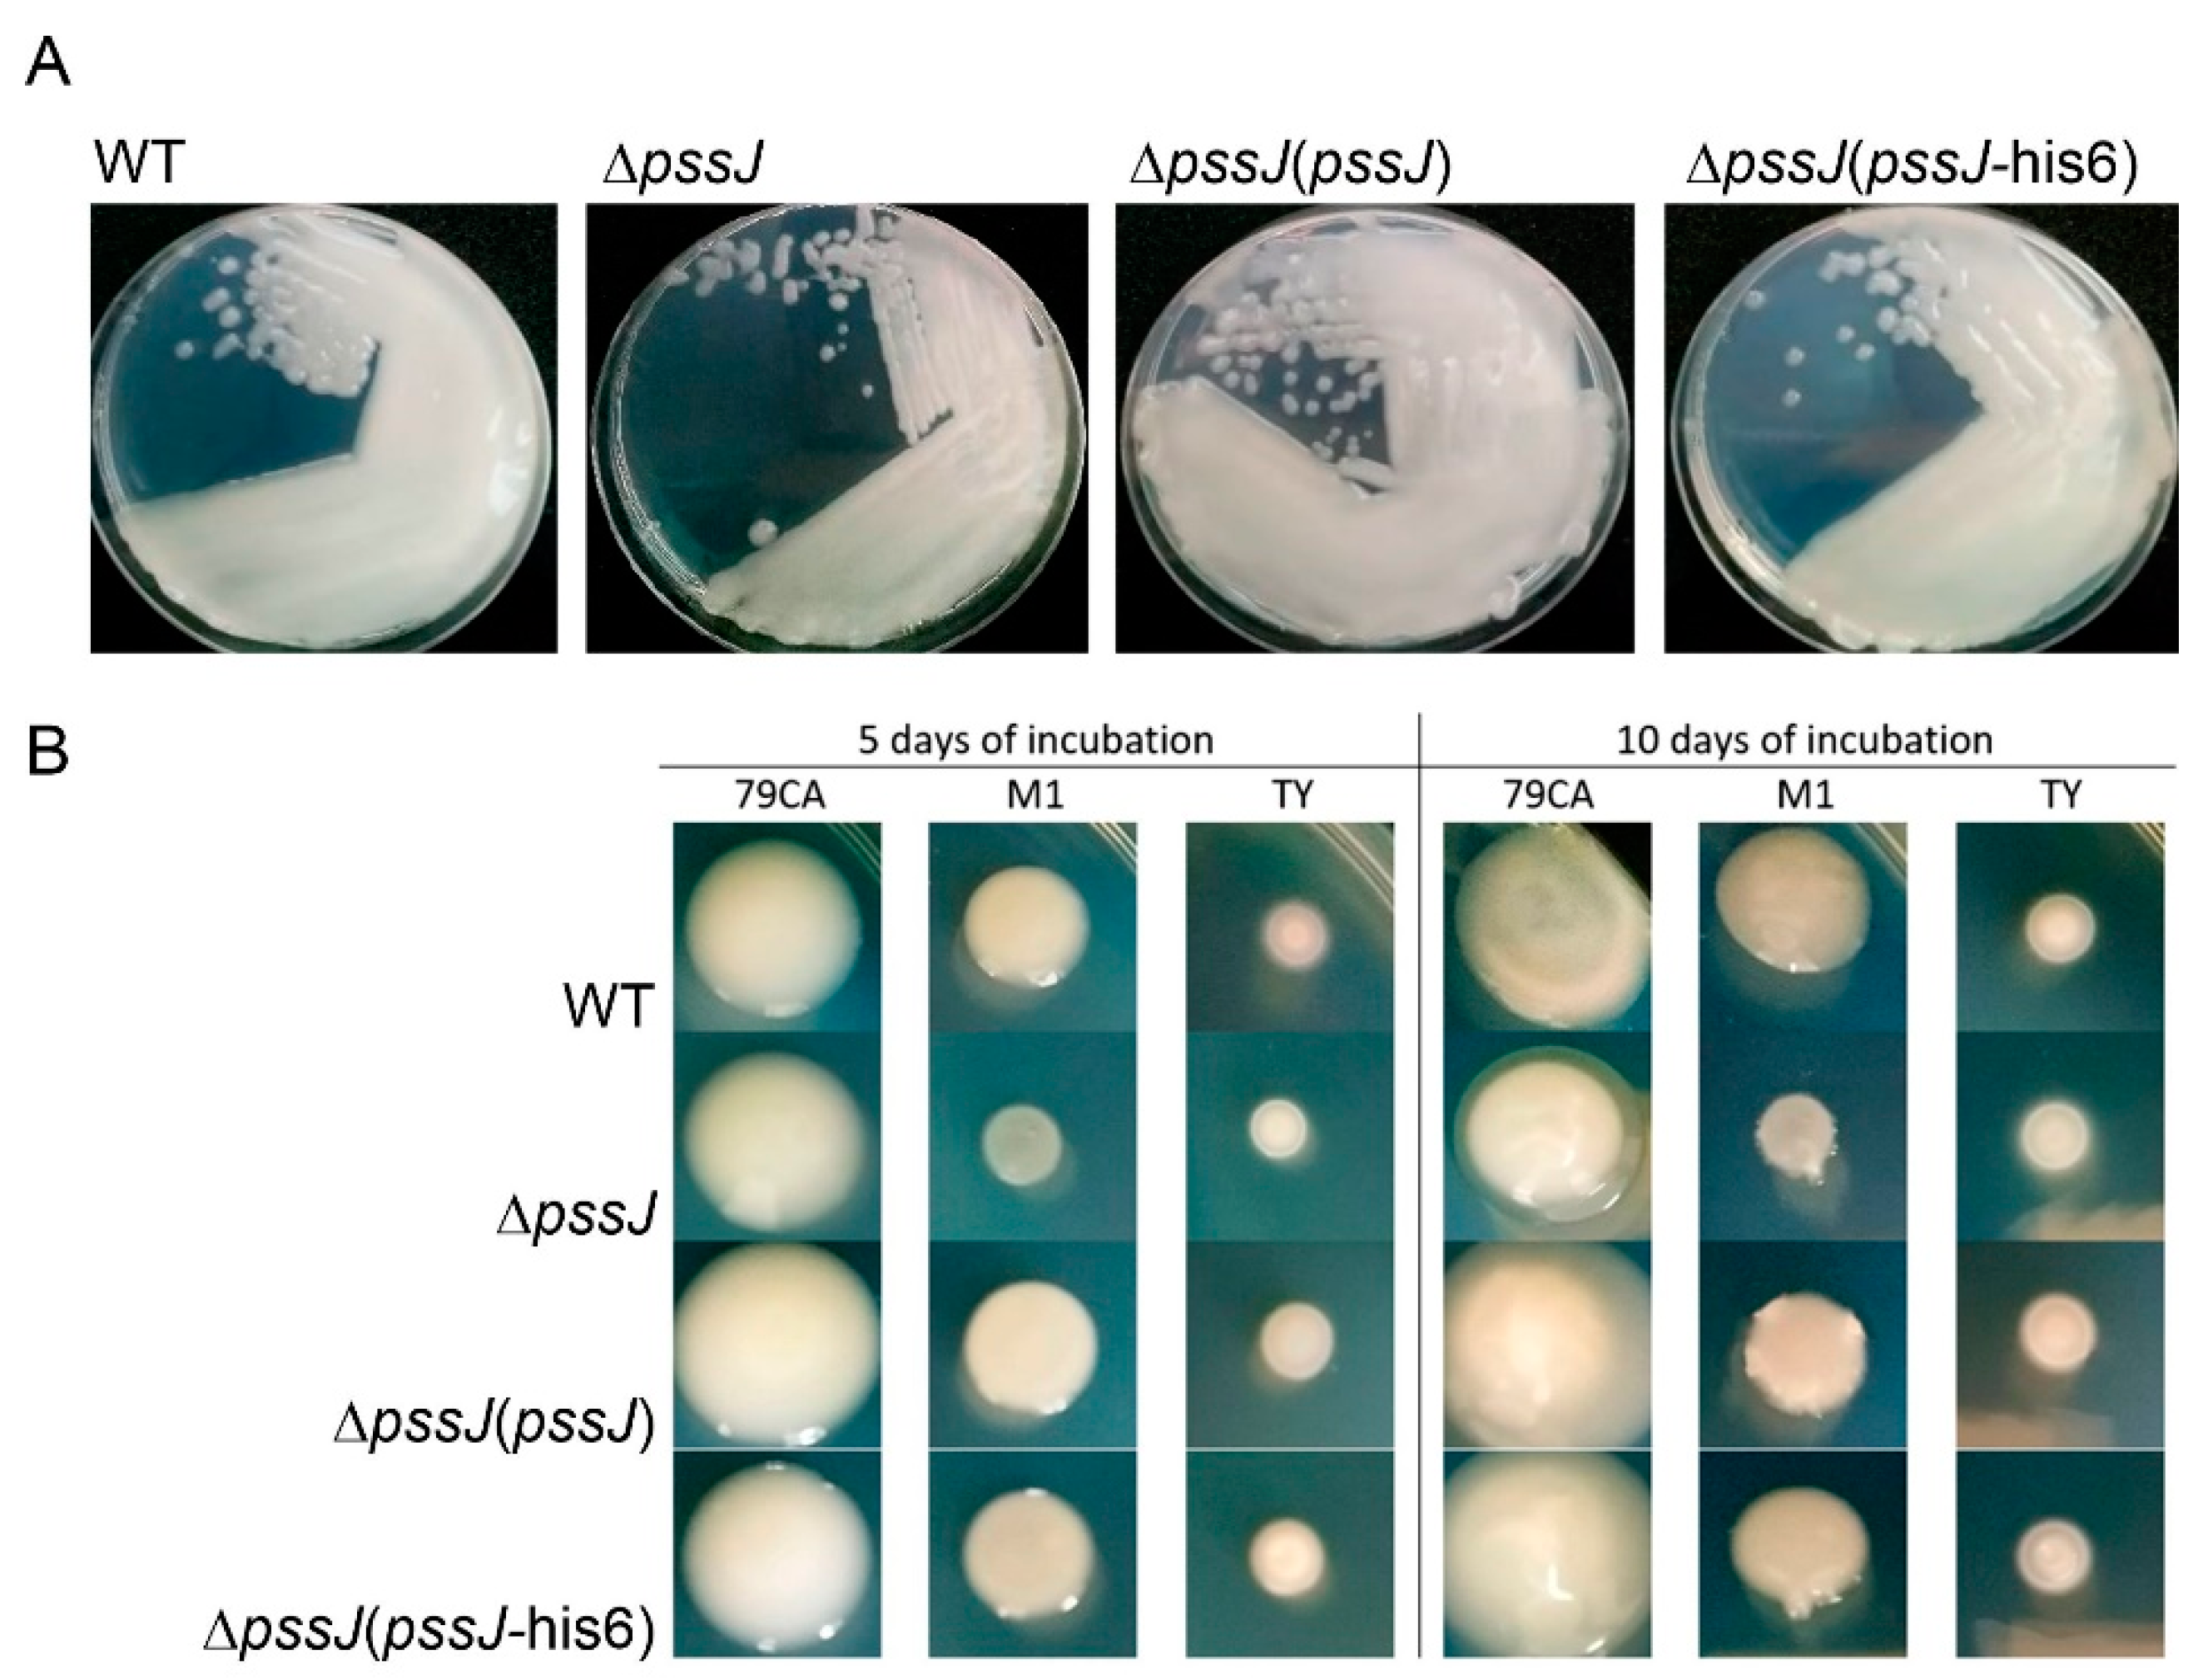
Ijms 21 07764 g004 Ijms 21 07764 g004

PssJ Is a Terminal Galactosyltransferase Involved in the Assembly of the Exopolysaccharide Subunit in Rhizobium leguminosarum bv. Trifolii
Abstract
1. Introduction
2. Results
2.1. PssJ Is Homologous to Galactosyltransferases
2.2. PssJ Is a Likely Biologically Active Galactosyltransferase Influencing EPS Biosynthesis
2.3. The Lack of Terminal Galactose in EPS Affects the Symbiotic and Free-Living Traits of the Mutant
2.4. PssJ May Play Its Role at the Membrane Interface by Interactions with Other Membrane GTs
3. Discussion
4. Materials and Methods
4.1. Bacterial Strains and Standard Culture Conditions
4.2. Bioinformatic Analyses
4.3. DNA Techniques
4.4. Construction of the ΔpssJ Mutant and PssJ Complemented Strains
4.5. Exopolysaccharide and Lipopolysaccharide Analyses
4.6. Plant Tests
4.7. Root Attachment Assay
4.8. Examination of Sensitivity to Stress Factors
4.9. Tolerance Against 30% Hydrogen Peroxide
4.10. Motility Tests
4.11. Biofilm Formation Assays
4.12. Preparation of His6-PssJ Inclusion Bodies
4.13. Preparation of Anti-PssJ Specific Chicken Antibodies
4.14. Rhizobium Cells Fractionation and Analyses
4.15. Bacterial Two-Hybrid System Assays
4.16. Statistical Analyses
Supplementary Materials
Author Contributions
Funding
Conflicts of Interest
References
- Castellane, T.C.L.; Lemos, M.V.F.; Lemosa, E.G.M. Exploring and utilization of some bacterial exopolysaccharide. Biopolym. Res. 2018, 2, 1000106. [Google Scholar]
- Donot, F.; Fontana, A.; Baccou, J.C.; Schorr-Galindo, S. Microbial exopolysaccharides: Main examples of synthesis, excretion, genetics and extraction. Carbohydr. Polym. 2012, 87, 951–962. [Google Scholar] [CrossRef]
- Ghosh, P.K.; Maiti, T.K. Structure of extracellular polysaccharides (EPS) produced by rhizobia and their functions in legume–bacteria symbiosis. Achiev. Life Sci. 2016, 10, 136–143. [Google Scholar] [CrossRef]
- Moscovici, M. Present and future medical applications of microbial exopolysaccharides. Front. Microbiol. 2015, 6, 1012. [Google Scholar] [CrossRef]
- Rehm, B.H. Bacterial polymers: Biosynthesis, modifications and applications. Nat. Rev. Microbiol. 2010, 8, 578–592. [Google Scholar] [CrossRef]
- Kawaharada, Y.; Kelly, S.; Nielsen, M.W.; Hjuler, C.T.; Gysel, K.; Muszyński, A.; Carlson, R.W.; Thygesen, M.B.; Sandal, N.; Asmussen, M.H.; et al. Receptor-mediated exopolysaccharide perception controls bacterial infection. Nature 2015, 523, 308–312. [Google Scholar] [CrossRef]
- Pellock, B.J.; Cheng, H.P.; Walker, G.C. Alfalfa root nodule invasion efficiency is dependent on Sinorhizobium meliloti polysaccharides. J. Bacteriol. 2000, 182, 4310–4318. [Google Scholar] [CrossRef]
- Skorupska, A.; Janczarek, M.; Marczak, M.; Mazur, A.; Król, J. Rhizobial exopolysaccharides: Genetic control and symbiotic functions. Microb. Cell. Fact. 2006, 5, 7. [Google Scholar] [CrossRef]
- Breedveld, M.W.; Cremers, H.C.; Batley, M.; Posthumus, M.A.; Zevenhuizen, L.P.; Wijffelman, C.A.; Zehnder, A.J. Polysaccharide synthesis in relation to nodulation behavior of Rhizobium leguminosarum. J. Bacteriol. 1993, 175, 750–757. [Google Scholar] [CrossRef]
- O’Neill, M.A.; Darvill, A.G.; Albersheim, P. The degree of esterification and points of substitution by O-acetyl and O-(3-hydroxybutanoyl) groups in the acidic extracellular polysaccharides secreted by Rhizobium leguminosarum biovars viciae, trifolii, and phaseoli are not related to host range. J. Biol. Chem. 1991, 266, 9549–9555. [Google Scholar]
- Philip-Hollingsworth, S.; Hollingsworth, R.I.; Dazzo, F.B. Host-range related structural features of the acidic extracellular polysaccharides of Rhizobium trifolii and Rhizobium leguminosarum. J. Biol. Chem. 1989, 264, 1461–1466. [Google Scholar]
- Robertsen, B.K.; Åman, P.; Darvill, A.G.; McNeil, M.; Albersheim, P. Host-symbiont interactions: V. The structure of acidic extracellular polysaccharides secreted by Rhizobium leguminosarum and Rhizobium trifolii. Plant Physiol. 1981, 67, 389–400. [Google Scholar] [CrossRef]
- González, V.; Santamaría, R.I.; Bustos, P.; Hernández-González, I.; Medrano-Soto, A.; Moreno-Hagelsieb, G.; Janga, S.C.; Ramírez, M.A.; Jiménez-Jacinto, V.; Collado-Vides, J.; et al. The partitioned Rhizobium etli genome: Genetic and metabolic redundancy in seven interacting replicons. Proc. Natl. Acad. Sci. USA 2006, 103, 3834–3839. [Google Scholar] [CrossRef] [PubMed]
- Król, J.E.; Mazur, A.; Marczak, M.; Skorupska, A. Syntenic arrangements of the surface polysaccharide biosynthesis genes in Rhizobium leguminosarum. Genomics 2007, 89, 237–247. [Google Scholar] [CrossRef] [PubMed]
- Young, J.P.; Crossman, L.C.; Johnston, A.W.; Thomson, N.R.; Ghazoui, Z.F.; Hull, K.H.; Wexler, M.; Curson, A.R.; Todd, J.D.; Poole, P.S.; et al. The genome of Rhizobium leguminosarum has recognizable core and accessory components. Genome Biol. 2006, 7, R34. [Google Scholar] [CrossRef] [PubMed]
- Lairson, L.L.; Henrissat, B.; Davies, G.J.; Withers, S.G. Glycosyltransferases: Structures, functions, and mechanisms. Annu. Rev. Biochem. 2008, 77, 521–555. [Google Scholar] [CrossRef]
- Lombard, V.; Golaconda Ramulu, H.; Drula, E.; Coutinho, P.M.; Henrissat, B. The carbohydrate-active enzymes database (CAZy) in 2013. Nucleic Acids Res. 2014, 42, D490–D495. [Google Scholar] [CrossRef]
- Lesk, A.M. NAD-binding domains of dehydrogenases. Curr. Opin. Struct. Biol. 1995, 5, 775–783. [Google Scholar] [CrossRef]
- Gloster, T.M. Advances in understanding glycosyltransferases from a structural perspective. Curr. Opin. Struct. Biol. 2014, 28, 131–141. [Google Scholar] [CrossRef]
- Schmid, J.; Heider, D.; Wendel, N.J.; Sperl, N.; Sieber, V. Bacterial glycosyltransferases: Challenges and opportunities of a highly diverse enzyme class toward tailoring natural products. Front. Microbiol. 2016, 7, 182. [Google Scholar] [CrossRef]
- Brockhausen, I. Crossroads between bacterial and mammalian glycosyltransferases. Front. Immunol. 2014, 5, 492. [Google Scholar] [CrossRef] [PubMed]
- Liang, D.M.; Liu, J.H.; Wu, H.; Wang, B.B.; Zhu, H.J.; Qiao, J.J. Glycosyltransferases: Mechanisms and applications in natural product development. Chem. Soc. Rev. 2015, 44, 8350–8374. [Google Scholar] [CrossRef] [PubMed]
- Ivashina, T.V.; Ksenzenko, V.N. Exopolysaccharide biosynthesis in Rhizobium leguminosarum: From genes to functions. In The Complex World of Polysaccharides; Karunaratne, D.N., Ed.; IntechOpen: Rijeka, Croatia, 2012; pp. 99–126. [Google Scholar] [CrossRef]
- Janczarek, M.; Rachwał, K. Mutation in the pssA gene involved in exopolysaccharide synthesis leads to several physiological and symbiotic defects in Rhizobium leguminosarum bv. trifolii. Int. J. Mol. Sci. 2013, 14, 23711–23735. [Google Scholar] [CrossRef] [PubMed]
- Ksenzenko, V.N.; Ivashina, T.V.; Dubeikovskaya, Z.A.; Ivanov, S.G.; Nanazashvili, M.B.; Druzhinina, T.N.; Kalinchuk, N.A.; Shibaev, V.N. The pssA gene encodes UDP-glucose: Polyprenyl phosphate-glucosyl phosphotransferase initiating biosynthesis of Rhizobium leguminosarum exopolysaccharide. Russ. J. Bioorg. Chem. 2007, 33, 150–155. [Google Scholar] [CrossRef]
- Pollock, T.J.; van Workum, W.A.; Thorne, L.; Mikolajczak, M.J.; Yamazaki, M.; Kijne, J.W.; Armentrout, R.W. Assignment of biochemical functions to glycosyl transferase genes which are essential for biosynthesis of exopolysaccharides in Sphingomonas strain S88 and Rhizobium leguminosarum. J. Bacteriol. 1998, 180, 586–593. [Google Scholar] [CrossRef]
- Janczarek, M.; Rachwał, K.; Turska-Szewczuk, A. A mutation in pssE affects exopolysaccharide synthesis by Rhizobium leguminosarum bv. trifolii, its surface properties, and symbiosis with clover. Plant Soil 2017, 417, 331–347. [Google Scholar] [CrossRef]
- Król, J.; Wielbo, J.; Mazur, A.; Kopcińska, J.; Łotocka, B.; Golinowski, W.; Skorupska, A. Molecular characterization of pssCDE genes of Rhizobium leguminosarum bv. trifolii strain TA1: pssD mutant is affected in exopolysaccharide synthesis and endocytosis of bacteria. Mol. Plant Microbe Interact. 1998, 11, 1142–1148. [Google Scholar] [CrossRef]
- Janczarek, M.; Rachwał, K.; Kopcińska, J. Genetic characterization of the Pss region and the role of PssS in exopolysaccharide production and symbiosis of Rhizobium leguminosarum bv. trifolii with clover. Plant Soil 2015, 396, 257–275. [Google Scholar] [CrossRef]
- Marczak, M.; Mazur, A.; Koper, P.; Żebracki, K.; Skorupska, A. Synthesis of rhizobial exopolysaccharides and their importance for symbiosis with legume plants. Genes 2017, 8, 360. [Google Scholar] [CrossRef]
- Ivashina, T.V.; Fedorova, E.E.; Ashina, N.P.; Kalinchuk, N.A.; Druzhinina, T.N.; Shashkov, A.S.; Shibaev, V.N.; Ksenzenko, V.N. Mutation in the pssM gene encoding ketal pyruvate transferase leads to disruption of Rhizobium leguminosarum bv. viciae-Pisum sativum symbiosis. J. Appl. Microbiol. 2010, 109, 731–742. [Google Scholar] [CrossRef]
- Mazur, A.; Król, J.E.; Wielbo, J.; Urbanik-Sypniewska, T.; Skorupska, A. Rhizobium leguminosarum bv. trifolii PssP protein is required for exopolysaccharide biosynthesis and polymerization. Mol. Plant Microbe Interact. 2002, 15, 388–397. [Google Scholar] [CrossRef] [PubMed]
- Niemeyer, D.; Becker, A. The molecular weight distribution of succinoglycan produced by Sinorhizobium meliloti is influenced by specific tyrosine phosphorylation and ATPase activity of the cytoplasmic domain of the ExoP protein. J. Bacteriol. 2001, 183, 5163–5170. [Google Scholar] [CrossRef] [PubMed]
- Mazur, A.; Marczak, M.; Król, J.E.; Skorupska, A. Topological and transcriptional analysis of pssL gene product: A putative Wzx-like exopolysaccharide translocase in Rhizobium leguminosarum bv. trifolii TA1. Arch. Microbiol. 2005, 184, 1–10. [Google Scholar] [CrossRef] [PubMed]
- Mazur, A.; Król, J.E.; Marczak, M.; Skorupska, A. Membrane topology of PssT, the transmembrane protein component of the type I exopolysaccharide transport system in Rhizobium leguminosarum bv. trifolii strain TA1. J. Bacteriol. 2003, 185, 2503–2511. [Google Scholar] [CrossRef]
- Marczak, M.; Mazur, A.; Król, J.E.; Gruszecki, W.I.; Skorupska, A. Lipoprotein PssN of Rhizobium leguminosarum bv. trifolii: Subcellular localization and possible involvement in exopolysaccharide export. J. Bacteriol. 2006, 188, 6943–6952. [Google Scholar] [CrossRef]
- Marczak, M.; Matysiak, P.; Kutkowska, J.; Skorupska, A. PssP2 is a polysaccharide co-polymerase involved in exopolysaccharide chain-length determination in Rhizobium leguminosarum. PLoS ONE 2014, 9, e109106. [Google Scholar] [CrossRef]
- Cooley, R.B.; Arp, D.J.; Karplus, P.A. Evolutionary origin of a secondary structure: π-helices as cryptic but widespread insertional variations of α-helices that enhance protein functionality. J. Mol. Biol. 2010, 404, 232–246. [Google Scholar] [CrossRef]
- Marx, C.J.; Lidstrom, M.E. Broad-host-range cre-lox system for antibiotic marker recycling in gram-negative bacteria. BioTechniques 2002, 33, 1062–1067. [Google Scholar] [CrossRef]
- Marczak, M.; Żebracki, K.; Koper, P.; Turska-Szewczuk, A.; Mazur, A.; Wydrych, J.; Wójcik, M.; Skorupska, A. Mgl2 Is a hypothetical methyltransferase involved in exopolysaccharide production, biofilm formation, and motility in Rhizobium leguminosarum bv. trifolii. Mol. Plant Microbe Interact. 2019, 32, 899–911. [Google Scholar] [CrossRef]
- Marczak, M.; Dźwierzyńska, M.; Skorupska, A. Homo- and heterotypic interactions between Pss proteins involved in the exopolysaccharide transport system in Rhizobium leguminosarum bv. trifolii. Biol. Chem. 2013, 394, 541–559. [Google Scholar] [CrossRef]
- Breton, C.; Snajdrová, L.; Jeanneau, C.; Koca, J.; Imberty, A. Structures and mechanisms of glycosyltransferases. Glycobiology 2006, 16, 29R–37R. [Google Scholar] [CrossRef]
- Breton, C.; Bettler, E.; Joziasse, D.H.; Geremia, R.A.; Imberty, A. Sequence-function relationships of prokaryotic and eukaryotic galactosyltransferases. J. Biochem. 1998, 123, 1000–1009. [Google Scholar] [CrossRef] [PubMed]
- Breton, C.; Imberty, A. Structure/function studies of glycosyltransferases. Curr. Opin. Struct. Biol. 1999, 9, 563–571. [Google Scholar] [CrossRef]
- Breedveld, M.W.; Zevenhuizen, L.P.; Zehnder, A.J. Synthesis of cyclic beta-(1,2)-glucans by Rhizobium leguminosarum biovar trifolii TA-1: Factors influencing excretion. J. Bacteriol. 1992, 174, 6336–6342. [Google Scholar] [CrossRef] [PubMed]
- Via, V.D.; Zanetti, M.E.; Blanco, F. How legumes recognize rhizobia. Plant Signal. Behav. 2016, 11, e1120396. [Google Scholar] [CrossRef]
- Downie, J.A. The roles of extracellular proteins, polysaccharides and signals in the interactions of rhizobia with legume roots. FEMS Microbiol. Rev. 2010, 34, 150–170. [Google Scholar] [CrossRef]
- Bertani, G. Studies on lysogenesis. I. The mode of phage liberation by lysogenic Escherichia coli. J. Bacteriol. 1951, 62, 293–300. [Google Scholar] [CrossRef]
- Kowalczuk, E.; Lorkiewicz, Z. Transfer of RP4 and R68.45 factors to Rhizobium. Acta Microbiol. Pol. 1979, 28, 221–229. [Google Scholar]
- Beringer, J.E. R factor transfer in Rhizobium leguminosarum. J. Gen. Microbiol. 1974, 84, 188–198. [Google Scholar] [CrossRef]
- Brown, C.M.; Dilworth, M.J. Ammonia assimilation by Rhizobium cultures and bacteroids. J. Gen. Microbiol. 1975, 86, 39–48. [Google Scholar] [CrossRef]
- Simon, R.; Priefer, U.; Pühler, A. A broad host range mobilization system for in vivo genetic engineering: Transposon mutagenesis in Gram negative bacteria. Nat. Biotechnol. 1983, 1, 784–791. [Google Scholar] [CrossRef]
- Sambrook, J.; Russell, D.W. Molecular Cloning: A Laboratory Manual, 3rd ed.; Cold Spring Harbor Laboratory Press: Cold Spring Harbor, NY, USA, 2001. [Google Scholar]
- Karimova, G.; Pidoux, J.; Ullmann, A.; Ladant, D. A bacterial two-hybrid system based on a reconstituted signal transduction pathway. Proc. Natl. Acad. Sci. USA 1998, 95, 5752–5756. [Google Scholar] [CrossRef] [PubMed]
- Chakravorty, A.K.; Zurkowski, W.; Shine, J.; Rolfe, B.G. Symbiotic nitrogen fixation: Molecular cloning of Rhizobium genes involved in exopolysaccharide synthesis and effective nodulation. J. Mol. Appl. Genet. 1982, 1, 585–596. [Google Scholar]
- Kovach, M.E.; Elzer, P.H.; Hill, D.S.; Robertson, G.T.; Farris, M.A.; Roop, R.M., II; Peterson, K.M. Four new derivatives of the broad-host-range cloning vector pBBR1MCS, carrying different antibiotic-resistance cassettes. Gene 1995, 166, 175–176. [Google Scholar] [CrossRef]
- Wielbo, J.; Golus, J.; Marek-Kozaczuk, M.; Skorupska, A. Symbiosis-stage associated alterations in quorum sensing autoinducer molecules biosynthesis in Sinorhizobium meliloti. Plant Soil 2010, 329, 399–410. [Google Scholar] [CrossRef]
- Zimmermann, L.; Stephens, A.; Nam, S.Z.; Rau, D.; Kübler, J.; Lozajic, M.; Gabler, F.; Söding, J.; Lupas, A.N.; Alva, V. A completely reimplemented MPI Bioinformatics Toolkit with a new HHpred server at its core. J. Mol. Biol. 2018, 430, 2237–2243. [Google Scholar] [CrossRef]
- Sievers, F.; Higgins, D.G. Clustal Omega for making accurate alignments of many protein sequences. Protein Sci. 2018, 27, 135–145. [Google Scholar] [CrossRef]
- Kelley, L.A.; Mezulis, S.; Yates, C.M.; Wass, M.N.; Sternberg, M.J. The Phyre2 web portal for protein modeling, prediction and analysis. Nat. Protoc. 2015, 10, 845–858. [Google Scholar] [CrossRef]
- Yachdav, G.; Kloppmann, E.; Kajan, L.; Hecht, M.; Goldberg, T.; Hamp, T.; Hönigschmid, P.; Schafferhans, A.; Roos, M.; Bernhofer, M.; et al. PredictProtein—An open resource for online prediction of protein structural and functional features. Nucleic Acids Res. 2014, 42, W337–W343. [Google Scholar] [CrossRef]
- Drozdetskiy, A.; Cole, C.; Procter, J.; Barton, G.J. JPred4: A protein secondary structure prediction server. Nucleic Acids Res. 2015, 43, W389–W394. [Google Scholar] [CrossRef]
- Kallberg, M.; Margaryan, G.; Wang, S.; Ma, J.; Xu, J. RaptorX server: A resource for template-based protein structure modeling. Methods Mol. Biol. 2014, 1137, 17–27. [Google Scholar] [CrossRef] [PubMed]
- Jones, D.T. Protein secondary structure prediction based on position-specific scoring matrices. J. Mol. Biol. 1999, 292, 195–202. [Google Scholar] [CrossRef] [PubMed]
- Ebina, T.; Suzuki, R.; Tsuji, R.; Kuroda, Y. H-DROP: An SVM based helical domain linker predictor trained with features optimized by combining random forest and stepwise selection. J. Comput. Aided Mol. Des. 2014, 28, 831–839. [Google Scholar] [CrossRef] [PubMed]
- Dobson, L.; Reményi, I.; Tusnády, G.E. CCTOP: A Consensus Constrained TOPology prediction web server. Nucleic Acids Res. 2015, 43, W408–W412. [Google Scholar] [CrossRef]
- Bagos, P.G.; Nikolaou, E.P.; Liakopoulos, T.D.; Tsirigos, K.D. Combined prediction of Tat and Sec signal peptides with hidden Markov models. Bioinformatics 2010, 26, 2811–2817. [Google Scholar] [CrossRef]
- Yu, N.Y.; Wagner, J.R.; Laird, M.R.; Melli, G.; Rey, S.; Lo, R.; Dao, P.; Sahinalp, S.C.; Ester, M.; Foster, L.J.; et al. PSORTb 3.0: Improved protein subcellular localization prediction with refined localization subcategories and predictive capabilities for all prokaryotes. Bioinformatics 2010, 26, 1608–1615. [Google Scholar] [CrossRef]
- Käll, L.; Krogh, A.; Sonnhammer, E.L. A combined transmembrane topology and signal peptide prediction method. J. Mol. Biol. 2004, 338, 1027–1036. [Google Scholar] [CrossRef]
- Krogh, A.; Larsson, B.; von Heijne, G.; Sonnhammer, E.L. Predicting transmembrane protein topology with a hidden Markov model: Application to complete genomes. J. Mol. Biol. 2001, 305, 567–580. [Google Scholar] [CrossRef]
- Shen, H.B.; Chou, K.C. Gneg-mPLoc: A top-down strategy to enhance the quality of predicting subcellular localization of Gram-negative bacterial proteins. J. Theor. Biol. 2010, 264, 326–333. [Google Scholar] [CrossRef]
- Reeve, W.; Tiwari, R.; Melino, V.; De Meyer, S.; Poole, P.S. Specialised genetic techniques for rhizobia. In Working with Rhizobia; Howieson, J., Dilworth, M.J., Eds.; Australian Centre for International Agricultural Research: Canberra, ACT, Australia, 2016; pp. 245–282. [Google Scholar]
- Garg, B.; Dogra, R.C.; Sharma, P.K. High-efficiency transformation of Rhizobium leguminosarum by electroporation. Appl. Environ. Microbiol. 1999, 65, 2802–2804. [Google Scholar] [CrossRef]
- Dubois, M.; Gilles, K.A.; Hamilton, J.K.; Rebers, P.A.; Smith, F. Colorimetric method for determination of sugars and related substances. Anal. Chem. 1956, 28, 350–356. [Google Scholar] [CrossRef]
- Apicella, M.A. Isolation and characterization of lipopolysaccharides. Methods Mol. Biol. 2008, 431, 3–13. [Google Scholar] [CrossRef] [PubMed]
- Tsai, C.M.; Frasch, C.E. A sensitive silver stain for detecting lipopolysaccharides in polyacrylamide gels. Anal. Biochem. 1982, 119, 115–119. [Google Scholar] [CrossRef]
- Nutman, P.S. Appendix III: The modified Fahraeus slide technique. In A Manual for the Practical Study of Root-Nodule Bacteria; Vincent, J.M., Ed.; Blackwell Scientific Publications: Oxford, UK, 1970; Volume 144–145. [Google Scholar]
- Polson, A.; von Wechmar, M.B.; van Regenmortel, M.H. Isolation of viral IgY antibodies from yolks of immunized hens. Immunol. Commun. 1980, 9, 475–593. [Google Scholar] [CrossRef]
- Grzywa, R.; Łupicka-Słowik, A.; Walczak, M.; Idzi, M.; Bobrek, K.; Boivin, S.; Gaweł, A.; Stefaniak, T.; Oleksyszyn, J.; Sieńczyk, M. Highly sensitive detection of cancer antigen 15-3 using novel avian IgY antibodies. Altex 2014, 31, 43–52. [Google Scholar] [CrossRef][Green Version]
- Łupicka-Słowik, A.; Psurski, M.; Grzywa, R.; Bobrek, K.; Smok, P.; Walczak, M.; Gaweł, A.; Stefaniak, T.; Oleksyszyn, J.; Sieńczyk, M. Development of adenosine deaminase-specific IgY antibodies: Diagnostic and inhibitory application. Appl. Biochem. Biotechnol. 2018, 184, 1358–1374. [Google Scholar] [CrossRef]
- Krehenbrink, M.; Edwards, A.; Downie, J.A. The superoxide dismutase SodA is targeted to the periplasm in a SecA-dependent manner by a novel mechanism. Mol. Microbiol. 2011, 82, 164–179. [Google Scholar] [CrossRef]
- Marczak, M.; Mazur, A.; Gruszecki, W.I.; Skorupska, A. PssO, a unique extracellular protein important for exopolysaccharide synthesis in Rhizobium leguminosarum bv. trifolii. Biochimie 2008, 90, 1781–1790. [Google Scholar] [CrossRef]

| Strain/Plasmid | Relevant Description | Reference |
|---|---|---|
| Escherichia coli | ||
| S17-1 | 294 derivative RP4-2-Tc::Mu-Km::Tn7 chromosomally integrated | [52] |
| DH5α | supE44 ΔlacU169 (Δ80 lacZΔM15) hsdR17 recA1 endA1 gyrA96 thi-1 relA1 | [53] |
| DHM1 | Reporter strain for BTH system; F- glnV44(AS) recA1 endA gyrA96 thi-1 hsdR17 spoT1 rfbD1 cya-854 | [54] |
| BL21(DE3) | F– ompT hsdSB (rB- mB-) gal dcm (DE3) | Novagen |
| Rhizobium leguminosarum bv. trifolii | ||
| RtTA1 | wild type strain, StrR, RifR | [55] |
| TA1ΔpssJ(GmR) | RtTA1 ΔpssJ::GmR | This work |
| TA1ΔpssJ[pCM157] | RtTA1 ΔpssJ carrying pCM157 cre expressing vector | This work |
| TA1ΔpssJ | RtTA1 ΔpssJ | This work |
| TA1ΔpssJ[pBKpssJ-C] | ΔpssJ carrying pBKpssJ-C (complemented mutant) | This work |
| TA1ΔpssJ[pBKpssJ-C-His6] | ΔpssJ carrying pBKpssJ-C-His6 (complemented mutant expressing His6-tagged PssJ) | This work |
| Plasmids | ||
| pET30c | ori pBR322, KanR, lacI, 6xHis-tag, S-tag | Novagen |
| pET30c-pssJ | pET30c derivative with 827-bp fragment comprising pssJ gene cloned in BamHI – XhoI | This work |
| pCM351 | ori ColE1, oriT, ApR, GmR, TcR, allelic exchange vector | [39] |
| pCM157 | ori IncP, oriT, TcR, cre expression vector | [39] |
| pBBR1MCS-2 | pBBR1 rep, mob, lacZα multi cloning site, KmR, broad-host-range cloning vector | [56] |
| pCGpssJ-U | pCM351 with 700 bp NdeI fragment comprising last 688 bp of pssK and pssK–pssJ intergenic region | This wok |
| pCGpssJ-UD | pCGpssJ-U with 570 bp ApaI–SacI fragment comprising pssJ–pssI intergenic region and 487 bp of pssI | This wok |
| pBKpssJ-C | pBBR1MCS-2 with 990 bp ApaI–XbaI fragment comprising last 88 bp of pssK, pssK–pssJ intergenic region, pssJ, and 68 bp downstream of pssJ | This work |
| pBKpssJ-C-His6 | pBBR1MCS-2 with 940 bp ApaI–XbaI fragment comprising last 88 bp of pssK, pssK–pssJ intergenic region, and pssJ without stop codon, equipped with His6-tag coding sequence and TAA stop codon | This work |
| pUT18 | Two-hybrid plasmid for cyaAT18 fusion construction, Apr | [54] |
| pUT18C | Two-hybrid plasmid for cyaAT18 fusion construction, Apr | [54] |
| pKNT25 | Two-hybrid plasmid for cyaAT25 fusion construction, Kmr | [54] |
| pKT25 | Two-hybrid plasmid for cyaAT25 fusion construction, Kmr | [54] |
| pUT18C-zip | Two-hybrid control plasmid, Apr | [54] |
| pKT25-zip | Two-hybrid control plasmid, Kmr | [54] |
| pUT18-pssA/pssC/pssD/pssE/pssF/pssG/pssH/pssI | pUT18 with DNA fragment of 792 bp, 981 bp, 459 bp, 477 bp, 885 bp, 975 bp, 969 bp, 945 bp comprising pssACDEFGHI genes cloned into XbaI-KpnI sites | This work |
| pUT18-pssS | pUT18 with DNA fragment of 1152 bp comprising pssS gene, cloned into XbaI-BamHI sites | This work |
| pUT18-pssJ | pUT18 with DNA fragment of 822 bp comprising pssJ gene, cloned into PstI-BamHI sites | This work |
| pUT18C-pssA/pssC/pssD/pssE/pssF/pssG/pssH/pssI | pUT18C with DNA fragment of 792 bp, 981 bp, 459 bp, 477 bp, 885 bp, 975 bp, 969 bp, 945 bp comprising pssACDEFGHI genes cloned into XbaI-KpnI sites | This work |
| pUT18C-pssS | pUT18C with DNA fragment of 1152 bp comprising pssS gene, cloned into XbaI-BamHI sites | This work |
| pUT18C-pssJ | pUT18C with DNA fragment of 822 bp comprising pssJ gene, cloned into PstI-BamHI sites | This work |
| pKT25-pssA/pssC/pssD/pssE/pssF/pssG/pssH/pssI | pKT25 with DNA fragment of 792 bp, 981 bp, 459 bp, 477 bp, 885 bp, 975 bp, 969 bp, 945 bp comprising pssACDEFGHI genes cloned into XbaI-KpnI sites | This work |
| pKT25-pssS | pKT25 with DNA fragment of 1152 bp comprising pssS gene, cloned into XbaI-BamHI sites | This work |
| pKT25-pssJ | pKT25 with DNA fragment of 822 bp comprising pssJ gene, cloned into PstI-BamHI sites | This work |
| pKNT25-pssA/pssC/pssD/pssE/pssF/pssG/pssH/pssI | pKNT25 with DNA fragment of 792 bp, 981 bp, 459 bp, 477 bp, 885 bp, 975 bp, 969 bp, 945 bp comprising pssACDEFGHI genes cloned into XbaI-KpnI sites | This work |
| pKNT25-pssS | pKT25 with DNA fragment of 1152 bp comprising pssS gene, cloned into XbaI-BamHI sites | This work |
| pKNT25-pssJ | pKT25 with DNA fragment of 822 bp comprising pssJ gene, cloned into PstI-BamHI sites | This work |
| pMEG65 | Vector with constitutively expressed gfp and RK2 stabilization fragment, Tcr | [57] |
Publisher’s Note: MDPI stays neutral with regard to jurisdictional claims in published maps and institutional affiliations. |
© 2020 by the authors. Licensee MDPI, Basel, Switzerland. This article is an open access article distributed under the terms and conditions of the Creative Commons Attribution (CC BY) license (http://creativecommons.org/licenses/by/4.0/).
Share and Cite
Marczak, M.; Wójcik, M.; Żebracki, K.; Turska-Szewczuk, A.; Talarek, K.; Nowak, D.; Wawiórka, L.; Sieńczyk, M.; Łupicka-Słowik, A.; Bobrek, K.; et al. PssJ Is a Terminal Galactosyltransferase Involved in the Assembly of the Exopolysaccharide Subunit in Rhizobium leguminosarum bv. Trifolii. Int. J. Mol. Sci. 2020, 21, 7764. https://doi.org/10.3390/ijms21207764
Marczak M, Wójcik M, Żebracki K, Turska-Szewczuk A, Talarek K, Nowak D, Wawiórka L, Sieńczyk M, Łupicka-Słowik A, Bobrek K, et al. PssJ Is a Terminal Galactosyltransferase Involved in the Assembly of the Exopolysaccharide Subunit in Rhizobium leguminosarum bv. Trifolii. International Journal of Molecular Sciences. 2020; 21(20):7764. https://doi.org/10.3390/ijms21207764
Chicago/Turabian StyleMarczak, Małgorzata, Magdalena Wójcik, Kamil Żebracki, Anna Turska-Szewczuk, Kamila Talarek, Dominika Nowak, Leszek Wawiórka, Marcin Sieńczyk, Agnieszka Łupicka-Słowik, Kamila Bobrek, and et al. 2020. "PssJ Is a Terminal Galactosyltransferase Involved in the Assembly of the Exopolysaccharide Subunit in Rhizobium leguminosarum bv. Trifolii" International Journal of Molecular Sciences 21, no. 20: 7764. https://doi.org/10.3390/ijms21207764
APA StyleMarczak, M., Wójcik, M., Żebracki, K., Turska-Szewczuk, A., Talarek, K., Nowak, D., Wawiórka, L., Sieńczyk, M., Łupicka-Słowik, A., Bobrek, K., Romańczuk, M., Koper, P., & Mazur, A. (2020). PssJ Is a Terminal Galactosyltransferase Involved in the Assembly of the Exopolysaccharide Subunit in Rhizobium leguminosarum bv. Trifolii. International Journal of Molecular Sciences, 21(20), 7764. https://doi.org/10.3390/ijms21207764

